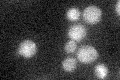
YDL140C
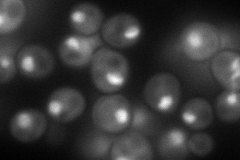
YDL140C
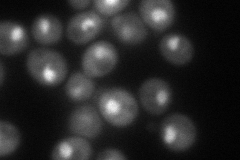
YDL140C

View description
RNA polymerase II largest subunit B220, part of central core; phosphorylation of C-terminal heptapeptide repeat domain regulates association with transcription and splicing factors; similar to bacterial beta-prime
Localization:
Intensity:
Fold change:
Significance:
-
C’ GFP library in SD
below threshold16.96 -
N' NOP1pr-GFP in SD
nucleolus144.545 -
N' TEF2pr-mCherry in SD
nucleus86.4837 -
N' NATIVEpr-GFP in SD

nucleus86.9905 -
N' TEF2pr-VC and Cyto-VN in SD

#N/A0 -
C’ GFP library in SD+DTT

cytosol15.850.93No -
C’ GFP library in SD+H2O2

cytosol17.991.06No -
C’ GFP library in Starvation Media

cytosol16.360.96No -
C’ GFP library on the background of Pup2-DaMP

below threshold -
C’ GFP library on the background of CCT mutant

below threshold20.38361.20133No
